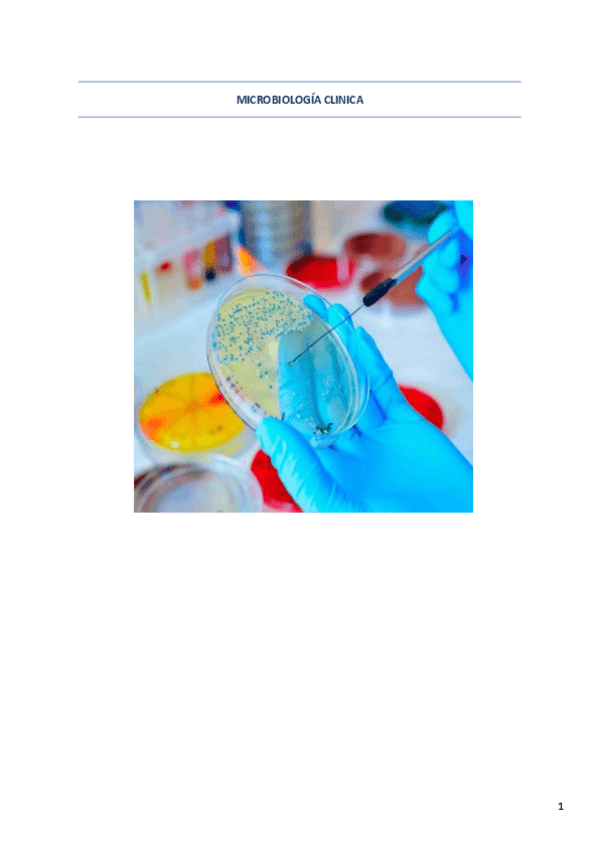

Microbiología clínica
He publicado nuevos apuntes de Microbiología clínica: MICROBIOLOGIA-1-EVALUACION.pdf
He publicado nuevos apuntes de Microbiología clínica: MICRO-2o-TRIMESTRE.pdf
He publicado nuevos apuntes de Microbiología clínica: cocos-negativos-neisseria.pdf
He publicado nuevos apuntes de Microbiología clínica: cuadro-cocos-positivos.pdf
He publicado nuevos apuntes de Microbiología clínica: bacilos-negativos-fermentadores-enterobacterias.pdf
He publicado nuevos apuntes de Microbiología clínica: bacilos-positivos.pdf
He publicado nuevos apuntes de Microbiología clínica: Bacilos-gram-negativos-exigentes-II.pdf
He publicado nuevos apuntes de Microbiología clínica: Bacilos-gram-negativos-exigentes-I.pdf
He publicado nuevos apuntes de Microbiología clínica: VibrioCampylobacter-Helicobacter-2.pdf
He publicado nuevos apuntes de Microbiología clínica: Microbiologia-clinica.pdf
apuntes
-
Temario entero de Microbiología Clínica.
He publicado nuevos apuntes de Microbiología clínica: Temario entero de Microbiología Clínica.

¡Estás al día!
Has visto todos los archivos